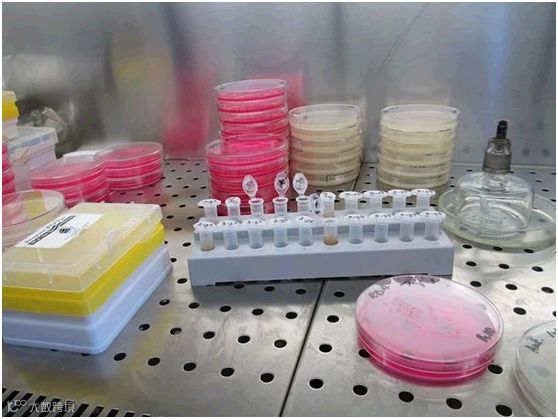

生态环境部印发《关于做好新型冠状病毒感染的肺炎疫情医疗污水和城镇污水监管工作的通知》,安排部署医疗污水和城镇污水监管工作,规范医疗污水应急处理、杀菌消毒要求,防止新型冠状病毒通过粪便和污水扩散传播。
新建临时医疗机构没有污水处理的固定设施,医疗污水严禁直接排放或处理未达标排放,应参照《医院污水处理技术指南》《医院污水处理工程技术规范》等相关标准规范,因地制宜建设临时性污水处理罐(箱),通过预消毒+生化处理+投加消毒剂等方式杀菌消毒。

据公开报道,新冠肺炎患者的粪便中已检测出病毒,提示除飞沫和接触传播外,新型冠状病毒可能存在新传播途径,比如“粪-口”“粪-呼吸”传播。国家卫健委通告将新冠肺炎纳入《中华人民共和国传染病防治法》规定的乙类传染病,并采取甲类传染病的预防和控制措施。按照规定要求,医院新冠肺炎患者的排泄物、分泌物、呕吐物等应采用专门容器收集并消毒处理。

新型冠状病毒检测对实验室要求严格,而粪大肠菌群的检测方法成熟,常被作为评价病原体灭活效果的替代指示物。此外,余氯含量也是间接表征消毒效果的重要指标。生态环境部《新型冠状病毒污染的医疗污水应急处理技术方案(试行)》规定,疫情期间,接收新冠肺炎患者的医疗机构产生的污水作为传染病医疗机构污水进行管控,应强化杀菌消毒,确保出水粪大肠菌群数等各项指标达到《医疗机构水污染物排放标准》(GB 18466-2005)的相关要求。
按照《医疗机构水污染物排放标准》(GB 18466-2005)的规定,应对医疗机构污水相关处理设施排出口和单位污水外排口开展水质监测和评价,并加密对废水中余氯指标监测频次。
(1) 需要佩戴一次性工作帽、一次性防护服、一次性乳胶手套、医用防护口(N95/KN95)、封闭式防雾型防护眼镜(若有条件可佩戴全面型呼吸防护器或正压式头套,则无需佩戴医用防护口罩和防护眼镜),必要时穿一次性鞋套,准备75%酒精或消毒湿巾、密封塑料袋等防护物资。现场监测时,应当全程佩戴全套个人防护用品,进入现场人员应相互检查,确认防护到位。医用防护口罩、全面型呼吸防护器、正压式头套出现脏污变形、损坏、有异味时需及时更换;余氯水样应当在现场快速监测,禁止带回实验室检测;水样监测后应当及时在现场用75%酒精对仪器设备进行擦拭消毒,仪器设备在返回单位入库前须再次用75%酒精进行擦拭消毒。
(2) 现场监测后,应当使用75%酒精或消毒湿巾对个人防护用品进行擦拭,避免长时间在外逗留;废弃的试纸条或试验耗材、防护用品等应当收集并用密封塑料袋收集,喷洒75%酒精消毒后封装;监测人员离开污染区域后,应立即取下一次性防护用品放入塑料袋内,喷洒75%酒精消毒后封装。所有封装后的废弃物均投放至就近的医疗废物专用收集装置内,进行集中无害化处理。防护眼镜、全面型呼吸防护器和正压式头套等防护用品应用75%酒精或1000mg/L含氯消毒剂浸泡消毒30分钟后,进行清水冲洗晾干后方可进行二次使用;监测人员应立即用消毒洗手液或肥皂在流水下洗手,并及时全面洗澡。

End
来源:海淀生态环境、环保科普365

合作共赢 共创辉煌——大湾区环境研究院与中国电信战略合作签约仪式圆满举行
筑巢引凤 共商大计——霍英东基金会永久董事霍震宇先生到访大湾区研究院
从未止步 一路向前——河南省新乡市机动车尾气遥感检测项目成功实施


